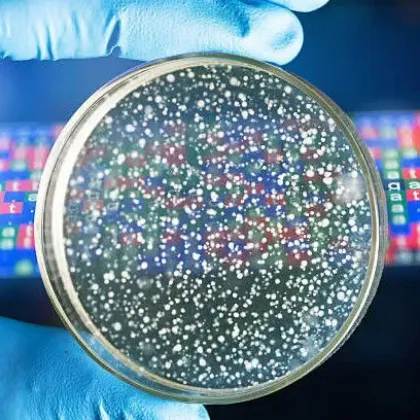
Imagen para la categoría Clonado y mutagénesis

Biología Molecular
En el mundo de la biología molecular, la precisión y la calidad son esenciales. En OneLab, te proporcionamos todo lo necesario para tus experimentos, desde reactivos para PCR hasta sistemas avanzados de electroforesis que aseguran análisis detallados de ADN, ARN y proteínas. Nuestros productos están diseñados para cada etapa, incluyendo la extracción, purificación, marcación y análisis de biomoléculas, ofreciendo resultados consistentes y reproducibles.
También te apoyamos con soluciones completas para el cultivo y análisis de células y bacterias, que integran equipos y reactivos de última generación. En OneLab, sabemos lo que tu laboratorio necesita para destacar en investigación y diagnóstico. Contáctanos en info@onelab.com.ar si tienes alguna consulta; estaremos encantados de ayudarte a encontrar la solución perfecta.
Membrana de Nitrocelulosa para Blotting 0,45µm, rollo de 30cm x 3,5m.
Membranas de transferencia de nitrocelulosa para Western Blot, transferencia de ADN, Dot Blot y Slot Blot. Se adaptan perfectamente a todos los sistemas de transferencia de proteínas, como la electrotransferencia, transferencia semiseca y la simple transferencia capilar. La elevada capacidad de unión de proteínas se combina con un bajo ruido de fondo gracias a las excelentes capacidades de saturación. La alta estabilidad de la membrana asegura un fácil manejo de la membrana de transferencia, incluso en condiciones de humedad. Alternativa a Bio Rad 1620115.
USD 538,68 + IVA (21%)
Cuba horizontal para SPCT con fondo para facilitar siembra
Diseñadas para maximizar su durabilidad, tiempo de uso y seguridad. Las cubas horizontales Numak son una excelente opción al momento de realizar análisis de proteínas, ARN y ADN sobre gel de agarosa. Están construídas en acrílico transparente . La gran capacidad para buffer no sólo asegura evitar el sobrecalentamiento, sino que además mantiene el valor de pH estable durante todo el proceso. Los electrodos removibles hacen que el reemplazo y mantenimiento del equipo sea rápido y sencillo. El fondo de las distintas bases presentan un coloreado que facilita la siembra. La tapa (transparente), que provee el equipo, previene la pérdida de liquido por evaporación. Utilizado en laboratorios de análisis clínicos, en universidades y en biología molecular. Presenta una auto desconexión cuando se retira la tapa.
USD 794,75 + IVA (10,5%)
Placa de 96 x 0,1ml Expell PCR plate x 25u.
CAPP ofrece placas de PCR sin faldón en el formato de 96 pocillos. Las placas de PCR Expell son autoclavables y altamente transparentes, lo que las hace especialmente óptimas para aplicaciones en las que la señal óptica qPCR proviene del fondo de la placa.
USD 184,03 + IVA (21%)
HeatSealer S200
Incluye adaptador de placas PCR. 100 – 230 V/50 – 60 Hz (AR).
USD 8.084,09 + IVA (10,5%)
HeatSealer S100
Incluye adaptador de placas PCR. 100 – 230 V/50 – 60 Hz (AR).
USD 5.631,37 + IVA (21%)
Baño de bloque seco MiniB
Baño de bloque seco Modelo MiniB, Marca Numak. Utilizado en biología molecular y en la extracción de ARN por el método automatizado.
USD 365,15 + IVA (10,5%)
Placas twin.tec PCR 96, sin faldón,azul (250µL),divisible, 20 uds.
Sin faldón, divisible, 250 µL. PCR clean, azul, 20 placas.
USD 376,15 + IVA (21%)
twin.tec PCR Plate 96, semi- skirted (pocillos incolores) Incoloro, 25 unidades
Con semi-faldón, 250 µL PCR clean, incoloro, 25 placas.
USD 326,12 + IVA (21%)
twin.tec PCR Plate 96, skirted (pocillos incoloros) Incoloro, 25 unidades
Con faldón, 150 µL. PCR clean, incoloro, 25 placas
USD 326,12 + IVA (21%)
Placa Deepwell 96/1000µL DNA, pocillos transparente x 20 u.
Innovadora tecnología DNA LoBind reduce la unión de la muestra a la superficie para garantizar la máxima recuperación de ácido nucleico y ofrecer la solución ideal para la preparación de muestras y el almacenaje a largo plazo.. DNA LoBind®, pocillos transparente, 1.000 µL, LoBind®. PCR clean, blanco, 20 placas (5 bolsas × 4 placas).
USD 419,29 + IVA (21%)
Placa Deepwell 96/1000µL Protein, pocillos transparente x 20 u.
Una combinación de tecnologías de fabricación especiales y lotes de polipropileno seleccionados aseguran una recuperación de moléculas de ADN/ARN de prácticamente el 100 %, sin revestimiento de superficies para eliminar el riesgo de contaminación de las muestras. Esto hace que las Eppendorf LoBind Plates sean ideales para aplicaciones en las que la recuperación de la muestra es clave, como la preparación de ácidos nucleicos para almacenaje a largo plazo en aplicaciones forenses, de microarrays y de NGS. Protein LoBind®, pocillos incoloro, 1.000 µL. PCR clean, blanco, 20 placas (5 bolsas × 4 placas)
USD 773,07 + IVA (21%)
Tubo Protein LoBind,PCR clean 200 unidades
Tubo Protein LoBind,PCR clean 200 unidades
USD 225,46 + IVA (21%)
Tapa para ThermoMixer F1.5
Para Eppendorf ThermoMixer® F0.5/F1.5/F2.0 y FP. Para Eppendorf SmartBlock 0,5 – 2,0 mL, placas, PCR 96, PCR 384 y DWP.
USD 317,65 + IVA (21%)
Bloque seco 120°C HB-120-S con bloque a elección
Baño seco con timer y hasta 120°C de temperatura. Con display y control digital. Incluye un bloque a eleccion
USD 554,86 + IVA (10,5%)
Transiluminador UV modelo UV-6
El transiluminador UV UV-6 se utiliza principalmente para observar los resultados de la electroforesis en gel de ácido nucleico (ADN / ARN) y la operación de corte de gel. Puede ser ampliamente utilizado en instituciones de investigación científica y empresas en los campos de biología molecular, genética molecular, medicina y salud, productos biológicos, agricultura.
USD 1.160,76 + IVA (10,5%)
100bp DNA Ladder x 5 viales de 500µl
100bp DNA Ladder es un marcador de peso molecular listo para usar, compuesto por fragmentos lineales de ADN doble cadena desde 100 bp hasta 1.5 kb. Incluye una banda de 500 bp con intensidad incrementada como referencia. Ideal para electroforesis en gel de agarosa en análisis de fragmentos pequeños. Almacenamiento a 4 °C o –20 °C.
USD 139,05 + IVA (21%)
100bp Plus DNA Ladder x 500µl
El 100 bp Plus DNA Ladder es un marcador de peso molecular premixado y listo para cargar, compuesto por doce fragmentos lineales de ADN bicatenario. Incluye buffer de carga 1× y genera bandas nítidas y definidas en agarosa. Su banda de referencia de 500 bp (100 ng/5 μl) ofrece una señal brillante para una cuantificación precisa del ADN.
USD 33,75 + IVA (21%)
1Kb DNA Ladder x 500µl
Trans2K®Plus II DNA Marker es una ladder de ADN premix lista para cargar, compuesta por ocho fragmentos lineales de doble cadena desde 100 bp hasta 8 kb. Incluye una banda de 750 bp con intensidad duplicada para una referencia clara en geles de agarosa. Ideal como estándar de peso molecular para electroforesis.
USD 25,65 + IVA (21%)
1Kb Plus DNA Ladder x 500µl
1KB Plus DNA Ladder es un marcador de peso molecular listo para usar, compuesto por fragmentos lineales de ADN doble cadena desde 300 bp hasta 10 kb. Incluye una banda de 2 kb con intensidad incrementada para facilitar la referencia visual en geles de agarosa. Ideal para electroforesis rutinaria y análisis de tamaño de fragmentos. Almacenamiento a 4 °C o –20 °C.
USD 40,50 + IVA (21%)